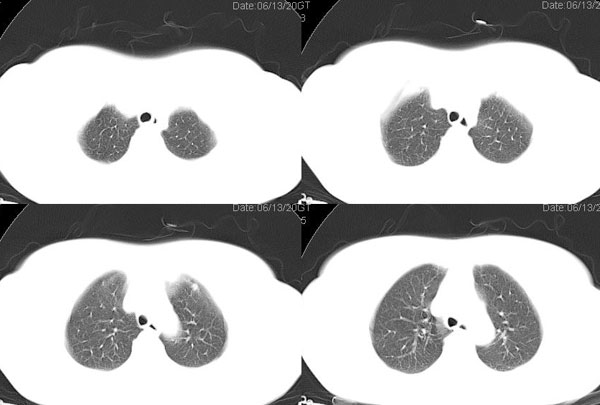

以下是引用jiangjing在2006-8-29 20:10:00的发言:[br]x线平片:左肺中野可见一约15mm*15mm的高密度影.[br] ct图像所见: 左肺下叶背段可见一直径约2.0cm类圆形肿块影,边缘模糊,有浅分叶,肿块周边可见沙粒样高密度影,肿块内可见空泡征,气管主支气管通畅,纵隔内未见明显肿大淋巴结影。 [br]诊断意见:左肺下叶背段可见一直径约2.0cm类圆形肿块影,肿块周边可见沙粒样高密度影,再结合2型糖尿病8年。多考虑:结核瘤。后经化验 ppd实验(++)[br]支持版主的考虑,病灶周围可见小点结影可疑卫星灶,但不完全除外肿瘤。建议增强及穿刺活检
| 欢迎光临 医影在线 (http://bbs.radida.com/bbs/) | Powered by Discuz! X3.2 |